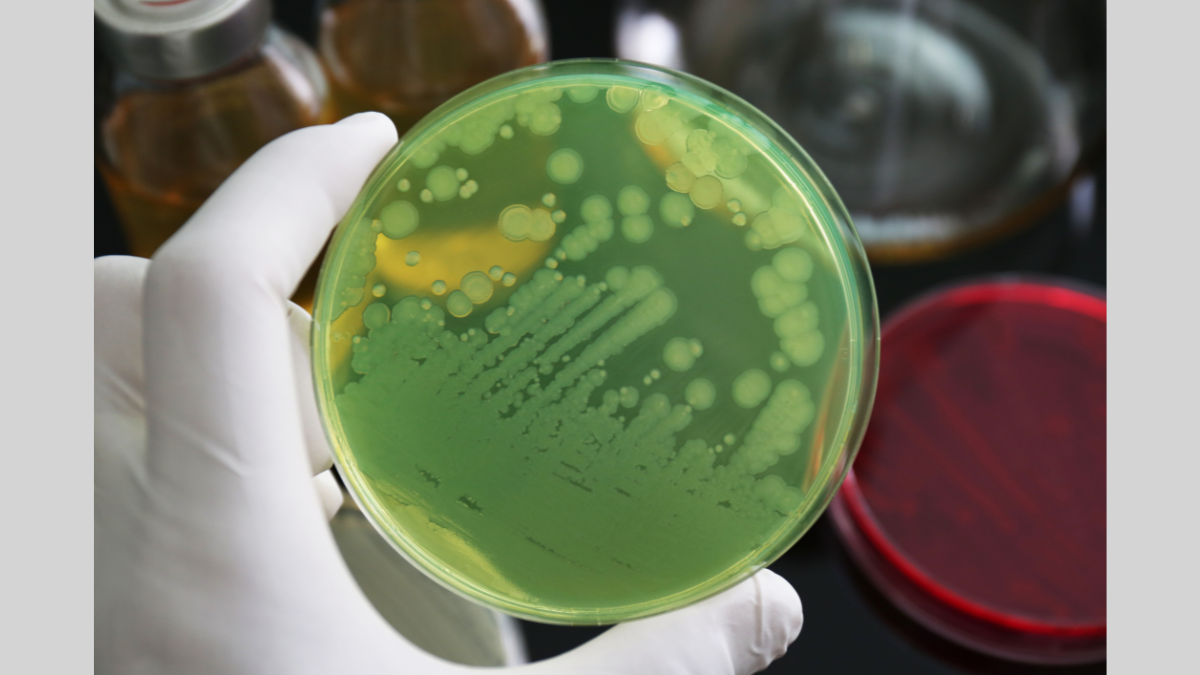

Reactive nitrogen species dominance is key in the fight against antimicrobial resistance
The balance between two types of molecules – reactive nitrogen species (RNS) and reactive oxygen species (ROS) – plays a crucial role in tackling drug-resistant bacteria, according to a new study from the University of Surrey.
In a study published in Microbiological Research, researchers from Surrey investigated how different RNS and ROS ratios affect harmful bacteria, including Staphylococcus aureus, Enterococcus faecalis, Escherichia coli, and Pseudomonas aeruginosa. Using advanced imaging and transcriptional analysis, they identified how these bacteria respond differently depending on the balance of these molecules.
The researchers found that this balance works similarly to dealing with weeds in a garden. RNS is like pulling weeds out by the roots – it removes them completely, preventing regrowth. But when ROS dominates, it's like just cutting the weeds at the surface; the bacteria may look weaker at first, but they can recover, form protective layers (biofilms), and become even harder to eliminate.
This discovery is important because drug-resistant infections are a growing global health threat, making many antibiotics less effective. Understanding how RNS and ROS interact at a molecular level could help scientists develop new treatments that enhance the body's natural defences and slow the spread of antimicrobial resistance (AMR).
Using a unique plasma device called ReCAP, designed by industrial manufacturer Fourth State, the research team exposed bacterial cultures to controlled mixtures of RNS and ROS. They grew the bacteria on liquid and solid media (a gel-like surface). Then, they used advanced imaging techniques, including scanning electron microscopy, to capture detailed changes in the bacteria's membranes.
In addition, they performed transcriptional analysis (a technique that reveals which genes are active or inactive in response to different conditions) to monitor how key genes responded to the different RNS/ROS ratios. This combined approach allowed the researchers to directly link specific molecular changes to the bacteria's survival strategies and provided clear evidence of how the balance between RNS and ROS dictates bacterial outcomes.
Related sustainable development goals
Media Contacts
External Communications and PR team
Phone: +44 (0)1483 684380 / 688914 / 684378
Email: mediarelations@surrey.ac.uk
Out of hours: +44 (0)7773 479911